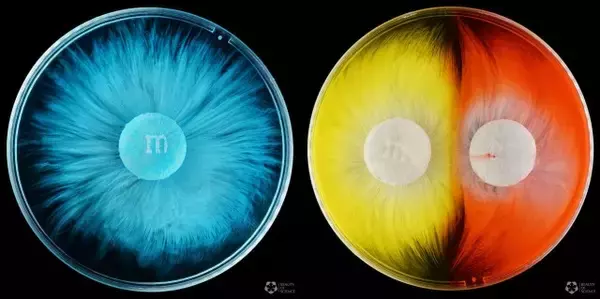

日本でも定着しつつあるM&M'sのチョコレートは、海外のお菓子特有のカラフルな色彩コーティングされた糖衣で覆われている。日本のマーブルチョコレートの海外バージョンといった感じかな。
この映像は、M&Mのカラフルな糖衣がペトリ皿の水に溶けていく様を早回しにしたものだが、様々な色とパターンが形成されていき、ずっと見ていられる美しさだ。
[動画を見る]
m&m's Dissolving in Water - 4K
この4Kビデオは、Sony α7R M2を使用して『Beauty of Science』が撮影したタイムラプス映像である。
どれ一つとして同じ溶け方をすることなく、世界に1つずつだけの大輪の花を咲かせているようだ。
[画像を見る]
[画像を見る]
[画像を見る]
2つのチョコが交じり合っていく様も美しい
[画像を見る]
[画像を見る]
これはずっと見ていられるやつ。
科学と芸術ってすごく近いところにあるんだね。
記事全文はこちら:ファンタスティック!M&M'sチョコレートの表面が溶けていく様子を早回しで http://karapaia.com/archives/52294984.html